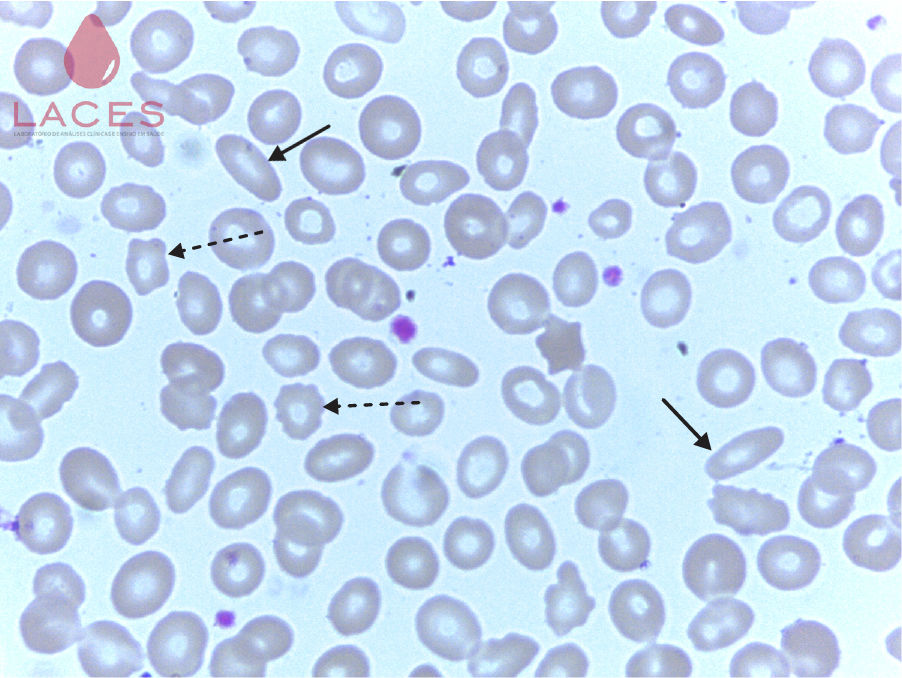
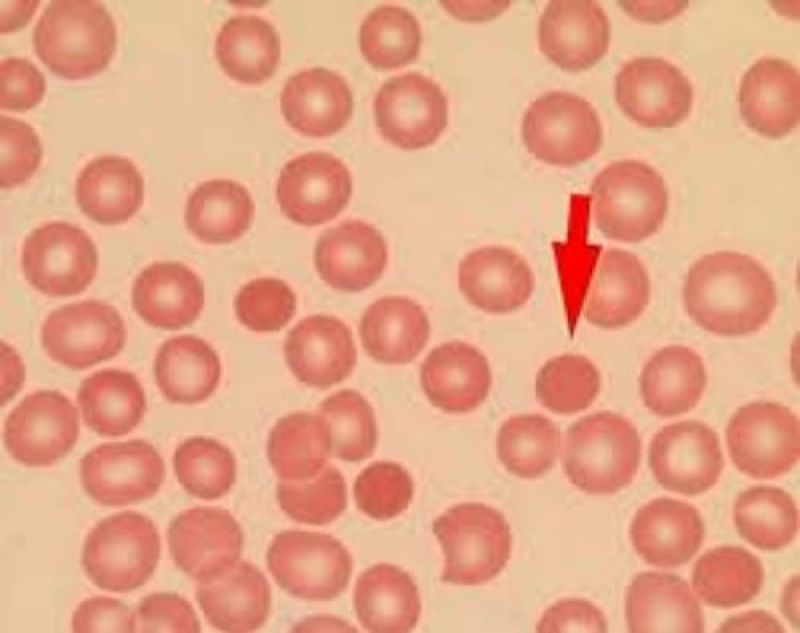
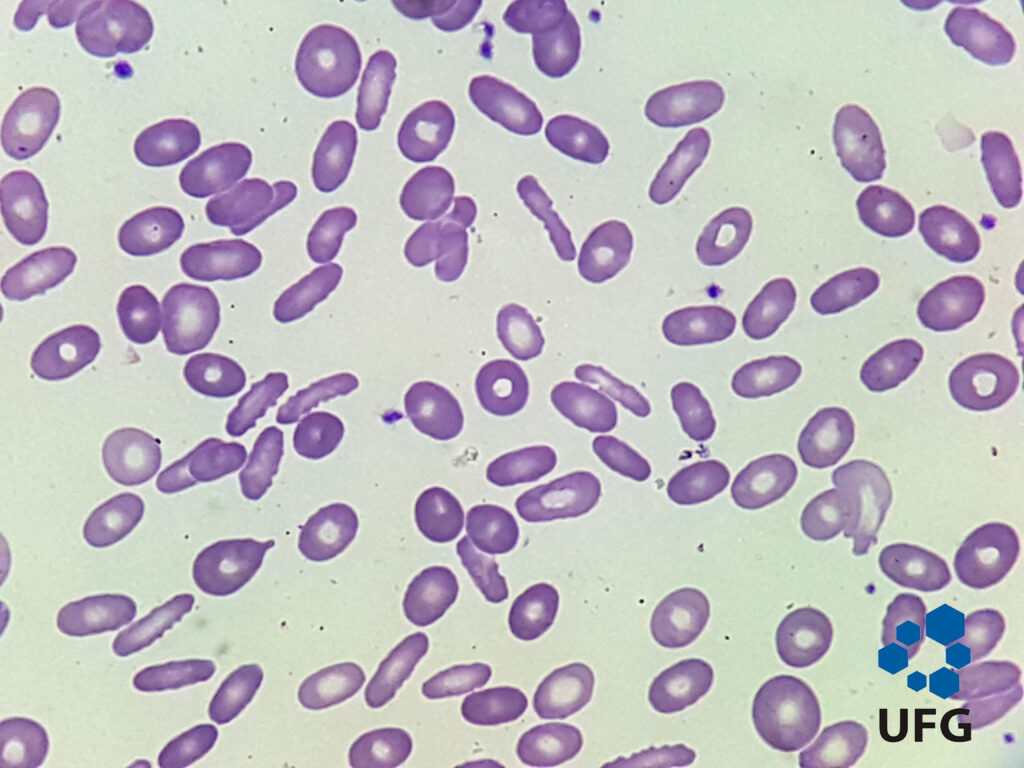
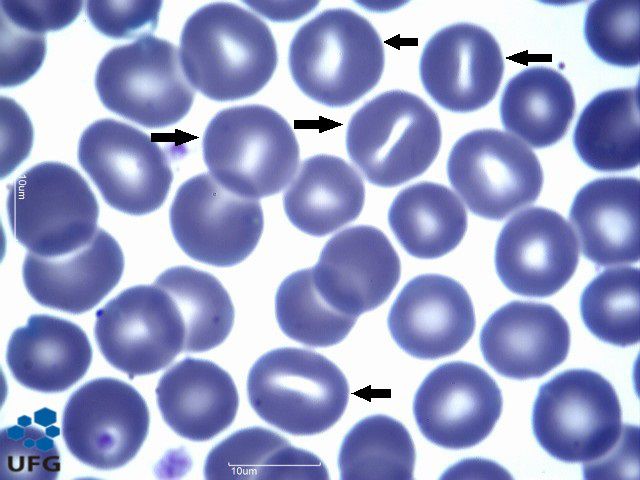
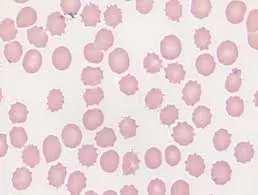
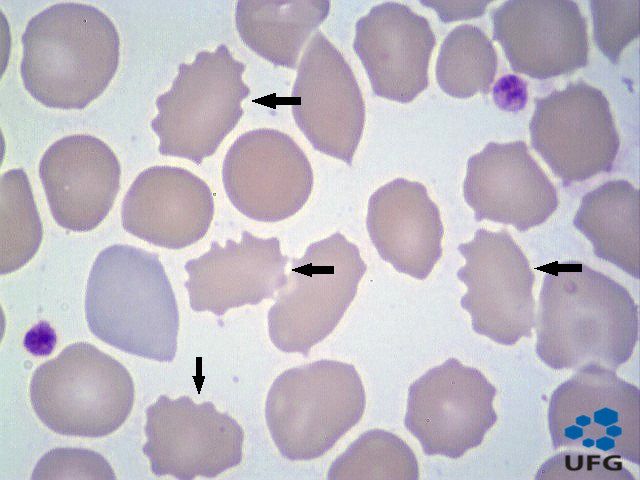
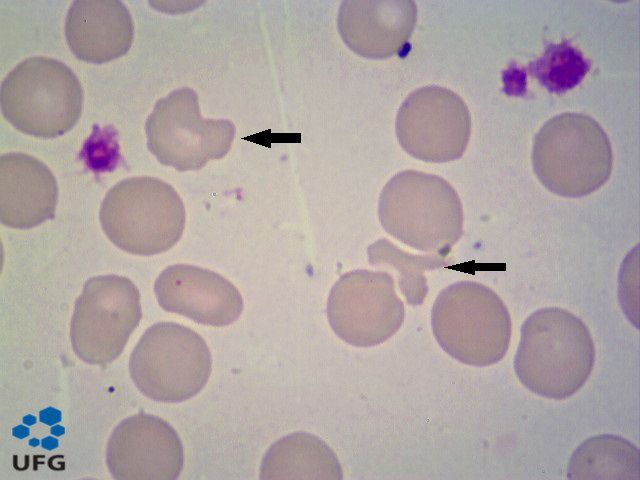
alteracoes-morfologicas-das-hemacias-biomedicina-esquizocitos

O que são Alterações Morfológicas das Hemácias?
As alterações morfológicas das hemácias fazem parte da rotina de análise em hematologia e são essenciais para interpretar corretamente um hemograma. Basicamente, elas envolvem mudanças no tamanho, formato das hemácias e coloração, podendo indicar desde condições benignas até doenças hematológicas mais complexas. Para quem está estudando biomedicina, entender essas alterações vai muito além de decorar nomes — é sobre correlacionar achados laboratoriais com o quadro clínico do paciente.
Quando falamos em alterações dos eritrócitos, estamos analisando padrões que ajudam a responder perguntas importantes: quais são as alterações presentes?, elas são homogêneas?, indicam deficiência nutricional ou algo mais grave?. A avaliação da morfologia das hemácias no esfregaço sanguíneo é uma habilidade prática que exige treino visual e raciocínio clínico. Esse tipo de análise complementa índices hematimétricos e oferece pistas valiosas sobre hemácias anormais causas e diagnósticos diferenciais.
Alterações no Tamanho dos Eritrócitos (Anisocitose)
A anisocitose refere-se à variação no tamanho das hemácias e é uma das alterações no hemograma mais comuns. No microscópio, você perceberá uma mistura de hemácias menores (microcíticas) e maiores (macrocíticas), o que indica que a produção eritrocitária não está homogênea. Essa condição aparece com frequência em anemias ferroprivas, megaloblásticas e em situações de recuperação medular.
Para o estudante, uma dica prática é correlacionar a anisocitose com o RDW (Red Cell Distribution Width). Quando o RDW está aumentado, há maior variação de tamanho, reforçando a presença dessa alteração. Além disso, observar o contexto clínico é essencial: deficiência de ferro geralmente apresenta microcitose, enquanto deficiência de vitamina B12 ou ácido fólico leva à macrocitose. Entender essas nuances ajuda a interpretar melhor as alterações sanguíneas eritrocitárias e evita conclusões precipitadas.
Alterações na Forma das Hemácias (Poiquilocitose)
A poiquilocitose diz respeito às mudanças no formato das hemácias, sendo um achado extremamente relevante na prática laboratorial. Diferente da anisocitose, aqui o foco não é o tamanho, mas sim o desenho das células. Existem diversos tipos de hemácias alteradas, cada um com significado clínico específico, o que torna esse tema fundamental para diagnósticos mais precisos.
Ao analisar um esfregaço, tente identificar padrões predominantes. A presença de formas específicas pode direcionar rapidamente o raciocínio clínico. Por exemplo, hemácias em formato de lágrima podem indicar infiltração medular, enquanto células fragmentadas sugerem processos hemolíticos. Dominar a morfologia das hemácias nesse nível permite que você vá além da teoria e realmente entenda o impacto das alterações morfológicas das hemácias no organismo.
Diferença entre Anisocitose e Poiquilocitose
Embora frequentemente apareçam juntas, anisocitose e poiquilocitose representam fenômenos distintos. A primeira está relacionada ao tamanho das células, enquanto a segunda envolve o formato. Essa diferenciação é essencial, principalmente em provas e na prática clínica, já que cada uma aponta para mecanismos fisiopatológicos diferentes.
Uma forma simples de memorizar é: anisocitose = tamanho, poiquilocitose = forma. Porém, na prática, você deve analisar ambas em conjunto. Um hemograma com microcitose e poiquilocitose, por exemplo, pode indicar anemia ferropriva avançada. Já macrocitose com formas anormais pode sugerir deficiência vitamínica. Entender essa relação amplia sua capacidade de interpretar alterações dos eritrócitos de forma integrada e estratégica.
Codócitos: o que são e quando aparecem
Os codócitos, também conhecidos como “células-alvo”, apresentam um aspecto característico com uma área central mais escura, lembrando um alvo. Eles são frequentemente observados em doenças hepáticas, talassemias e após esplenectomia. Sua presença está relacionada a alterações na membrana celular e no conteúdo de hemoglobina.
Para identificar codócitos com mais facilidade, ajuste o foco do microscópio e procure por células com distribuição desigual de hemoglobina. Eles são um ótimo exemplo de como o formato das hemácias pode fornecer pistas diagnósticas importantes. Ao estudar quais são as alterações, sempre associe a morfologia ao contexto clínico para consolidar o aprendizado.

Esferócitos: causas e significado clínico
Os esferócitos são hemácias mais arredondadas e sem a palidez central típica. Eles surgem principalmente na esferocitose hereditária e em anemias hemolíticas autoimunes. Por terem menor área de superfície, são mais frágeis e propensos à destruição no baço.
Na prática, essas células podem ser confundidas com artefatos, então atenção ao padrão geral do esfregaço. A presença significativa de esferócitos geralmente indica um processo hemolítico ativo. Esse é um dos exemplos mais clássicos de alterações morfológicas das hemácias associadas a doenças específicas.
Eliptócitos e Ovalócitos: diferenças e diagnóstico
Eliptócitos e ovalócitos apresentam formato alongado, mas com pequenas diferenças estruturais. Eles são comuns em anemias ferroprivas e em algumas condições hereditárias, como a eliptocitose hereditária. Apesar de parecerem simples, sua identificação correta pode ajudar muito no diagnóstico diferencial.
Para estudantes, a dica é observar a frequência dessas células. Quantidades pequenas podem não ter relevância clínica, mas quando predominantes, indicam alteração significativa na produção eritrocitária. Esses detalhes fazem toda a diferença na análise da morfologia das hemácias.

Fundamentos em Hematologia – Hoffbrand & Moss – 7° Edição – Editora Artmed

Tratado de Hematologia – Vanderson Rocha – 2° edição – Editora Atheneu
Estomatócitos: o que indicam
Os estomatócitos possuem uma palidez central em forma de “boca”. Eles podem aparecer em doenças hepáticas, alcoolismo e algumas condições hereditárias. Também podem surgir como artefato, o que exige cuidado na interpretação.
Uma boa prática é sempre correlacionar com outros achados laboratoriais. Se houver suspeita de artefato, revise a técnica de preparação do esfregaço. Esse tipo de atenção aos detalhes é essencial para evitar erros na análise das alterações no hemograma.
Drepanócitos (Células Falciformes): relação com anemia falciforme
Os drepanócitos têm formato de foice e são característicos da anemia falciforme. Eles surgem devido à alteração na hemoglobina, que se polimeriza em condições de baixa oxigenação. Essa mudança afeta diretamente o formato das hemácias e sua funcionalidade.
Além de identificar essas células, é importante entender seu impacto clínico, como crises vaso-oclusivas. Esse é um exemplo clássico onde a poiquilocitose tem implicações diretas na fisiopatologia da doença.
É muito importante que você não se esqueça da relação dos drepanócitos com anemia falciforme, pois é o tipo de alteração de hemácia que mais cai em concursos e provas! Também aparece como ”hemácias falciformizadas”.

Dacriócitos: causas comuns
Os dacriócitos têm formato de lágrima e estão associados a doenças da medula óssea, como mielofibrose. Também podem aparecer em anemias graves. Sua presença geralmente indica que a medula está sendo “pressionada” ou infiltrada.
Para quem está aprendendo, esse é um ótimo exemplo de como a morfologia das hemácias reflete alterações estruturais profundas no organismo. Sempre que encontrar dacriócitos, pense em doenças medulares.

Equinócitos: artefato ou patologia?
Os equinócitos apresentam projeções regulares na membrana. Muitas vezes, são artefatos causados por má preparação da lâmina, mas também podem estar associados a uremia e outras condições.
A principal dica aqui é: não diagnostique baseado em uma única célula. Avalie o padrão geral e considere a possibilidade de erro técnico. Isso é essencial para interpretar corretamente as alterações morfológicas das hemácias.
Acantócitos: doenças associadas
Diferente dos equinócitos, os acantócitos possuem projeções irregulares. Eles estão associados a doenças hepáticas graves e distúrbios neurológicos. Sua identificação exige atenção, pois podem ser confundidos com outras células espiculadas.
Esses casos mostram como o estudo das alterações sanguíneas eritrocitárias exige prática e olhar treinado. Quanto mais você observa, mais fácil se torna diferenciar padrões.
Esquizócitos: quando se preocupar
Os esquizócitos são fragmentos de hemácias e indicam destruição mecânica, como ocorre em anemias hemolíticas microangiopáticas. Sua presença é um sinal de alerta e pode indicar condições graves, como coagulação intravascular disseminada.
Na prática laboratorial, a quantificação de esquizócitos é extremamente importante. Eles representam uma das alterações dos eritrócitos mais críticas e exigem atenção imediata.
Referências Bibliográficas
- HOFFBRAND, A. V.; MOSS, H. Fundamentos em Hematologia de Hoffbrand. [s.l.] Artmed Editora, 2018.
- DE ALMEIDA, Mabel Soares; DE MELO, Catarinne Xavier; ALMEIDA, Maria Margareth C. CAUSAS DE ALTERAÇÕES MORFOLÓGICAS NOS GLÓBULOS VERMELHOS QUE COMPROMETEM O RESULTADO DO LAUDO CLÍNICO. Revista de Ciências da Saúde Nova Esperança, v. 10, n. 1, p. 84–91, 2012.
- FORMATO, Das et al. ANEMIA FALCIFORME, UMA DOENÇA CARACTERIZADA PELA ALTERAÇÃO NO. Disponível em: <https://portal.unisepe.com.br/unifia/wp-content/uploads/sites/10001/2018/06/14anemia_falciforme.pdf>. Acesso em: 8 abr. 2026.




